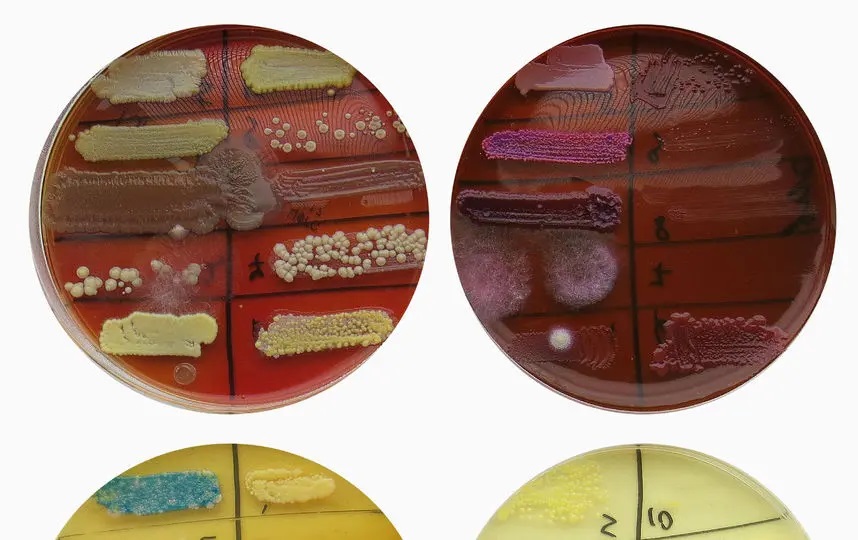
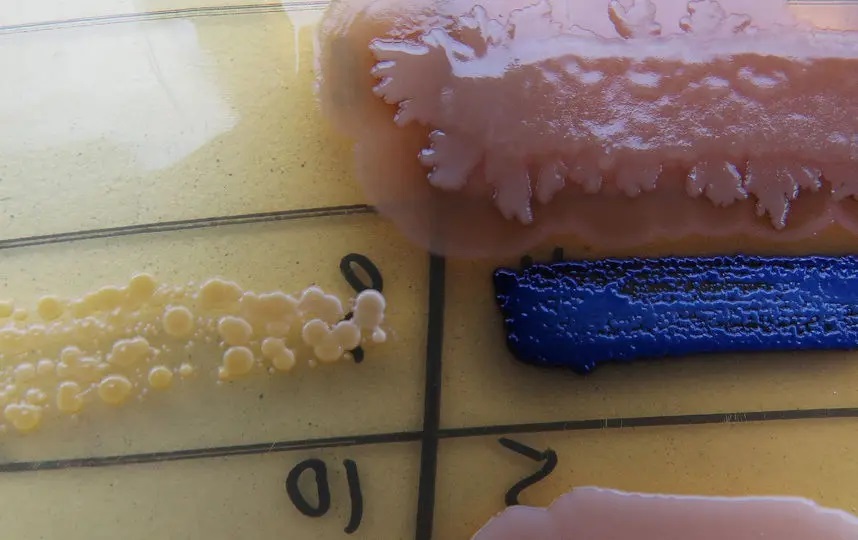
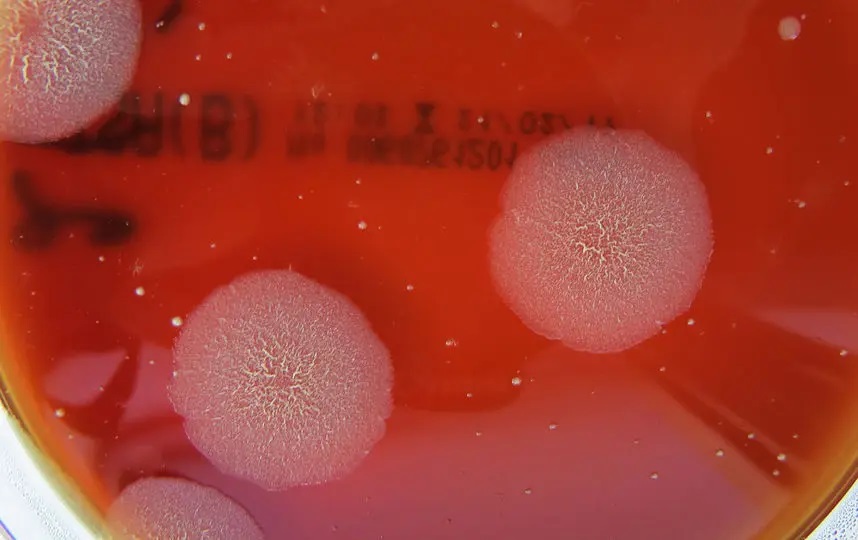
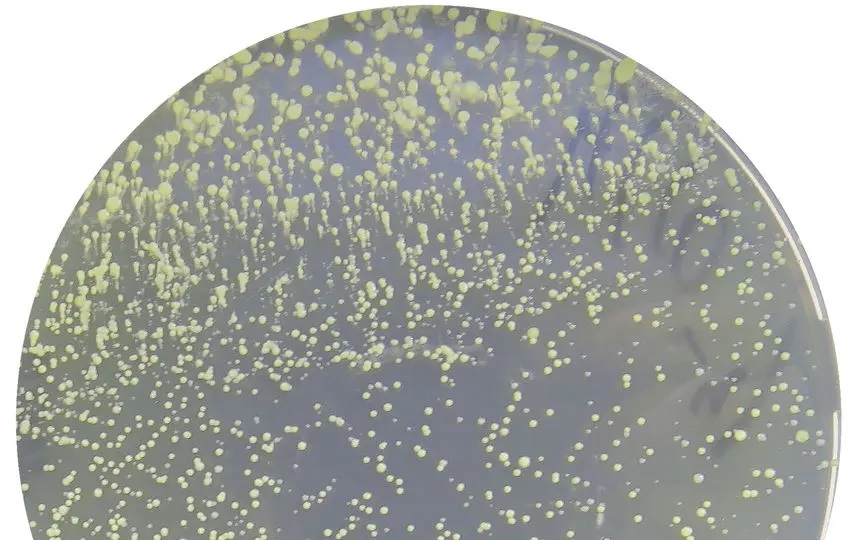

Что показал бактериальный анализ
московских икон?
Дарья Федорова - автор проекта
"Путешествие человеческого микробиома", в рамках
которого она взяла на анализ смывы с икон из московских
церквей. Что показал эксперимент и к каким выводам она
пришла?


Микроорганизмы могут образовывать причудливые цветом и
формой колоний на питательных средах (фото к теме статьи
не относится)
"Мысль посмотреть на то, что остается на
иконе после поцелуев верующих, но скрыто от наших глаз,
возникла совершенно случайно. Я просто подумала, что
круто было бы собрать образцы с икон из разных церквей,
вырастить эти микроорганизмы и визуализировать. Я верю в
Бога и в то, что каждый человек и есть Бог, а значит, и
в людей я верю. Мне посчастливилось найти
единомышленника - научную сотрудницу из лаборатории,
которая вместе со мной ходила по церквям. Изначально я
хотела сравнить смывы с икон из храмов в центре города
со смывами из более отдаленных и не очень посещаемых, но
это вылилось бы в недельное путешествие, а мне хотелось
поскорее начать работать с материалом. Поэтому мы просто
приехали на "Третьяковскую" и заходили во все
попадавшиеся нам на пути церкви.
***
Примечание редакции проекта "К
Истине". События данной статьи происходили в
далеком 2017 году за три года на начала эпидемии
Covid-19. Полагаю, что это
было своеобразным божьим предупреждением, которое
потонуло и в церковном верунстве, и в церковном
мракобесии, и лицемерии безгранично лицемерного Вахтанга
Кипшиде (см. ниже).
Между тем, уже столетия (!) назад, когда
еще не открыли бактерии и вирусы, адекватные люди в
светской
власти понимали, что для прекращения эпидемии нужно
закрывать все (!) места массового собрания людей, включая
храмы. И это было совершенно не очевидно для многих
наших епископов и священников и тем более мирян сейчас,
в XXI веке, во время массовой
грамотности и высокого развития медицины!
Там, где имеет место большое скопление
народа, обязательно имеет место большое скопление
бактерий, вирусов и грибков, что воздушно-капельным
путем выделяет это скопление народа. И нужно отдавать
здравый отчет, что нести себе в рот. Нужно ли целовать
крест, что до тебя только что поцеловало 150 человек,
многие и которых с признаками ОРВИ? Тем более что
Евангелие от нас это не требует как обязательное условие
спасения.
А священнослужителям не обманывать ни
себя ни людей.
Статья показывает, что на иконах
остаются жизнеспособные бактерии, их мгновенно не
уничтожает "небесная благодать".


Миллионы и миллионы индусов купаются в
одной и самых грязных грех мира - Ганге, они даже пьют
это воду! Массово умирают, болеют? Потому что Ганг
"священная река"? И боги Индии защищают верующих? Нет.
Просто у аборигенов невероятный иммунитет там, где белый
человек с Европы зайдет по щиколотку, тут же выйдет, и
через месяц умрет от гепатита и холеры
А Причастие? Чтобы там не говорили у нас
Церкви - люди принимают то, что имеет вид
разбавленного кагора и хлеба, и таковым по материальной
структуре является. Отвратительный, паленый кагор
(было дело, что бутылке обнаружили дохлую мышь - и это
правда этой жизни) - и люди будут пить
отвратительную по вкусу "кровь", кислые и невкусные
просфоры (я пробовал такие отвратительные на вкус
просфоры в одном томской храме) - таким будет и "плоть"
по вкусу. Мне рассказывал священник, что будучи
диаконом, ему приходилось употреблять заплесневевшие (!)
Дары из дарохраниельницы. "Великая святыня" же! Сжечь
или погребсти нельзя... Ешь диакон. А потом имело место
расстройство ЖКТ. И другого от заплесневелого хлеба
произойти и не могло!
***
Ей посчастливилось найти единомышленника
- научную сотрудницу из лаборатории, которая вместе со
ней ходила по церквям. Изначально она хотела сравнить
смывы с икон из храмов в центре города со смывами из
более отдаленных и не очень посещаемых, они приехали на
"Третьяковскую" и заходили во все попадавшиеся им на
пути церкви. Кстати все следы видны невооруженным
взглядом - на одной из икон был замечен даже блеск для
губ.
Сначала мы вызвали недоумение: какие-то
непонятные люди с длинными ушными палочками пришли в
церковь что-то собрать. Мы решили подойти к
служительнице и спросить разрешения взять бактериальный
анализ, хотя понимали, что эта идея была обречена на
провал. Она посмотрела на нас испуганным взглядом, тут
же взяла дезинфектор и салфетку, поняв, что нужно пойти
и срочно протереть стекла, и отправила нас за
благословением на этот анализ к батюшке. Батюшки в храме
не оказалось, выяснилось, что будет он только через
неделю, но мы были настроены решительно и ждать не
собирались. У меня уже в одном рукаве был шприц с
физраствором, в другом - тупфер и камера наготове.
Мы обратились за разрешением к
охраннику, который ответил, что наши эксперименты потом
выльются в эксперименты с ним, и выпроводил нас с богом.
После этого мы решили просто заходить в церкви и, не
спрашивая разрешений, брать смывы. Потому что, если я
это стекло целую, я имею право знать, что на нем. Тем
более что эти следы видны невооруженным взглядом - на
одной из икон был даже блеск для губ.
Целью нашего эксперимента не было
показать, что церковь - это одна большая бактерия. Этот
проект не отрицает Бога, он о вовлеченности людей.
Понятное дело, что вера тех, кто каждый день ходит в
церковь, сильнее мысли о том, что икона грязная. Моя
напарница сама целовала иконы в церквях. После проекта
сказала, что в следующий раз дважды перед этим подумает.
Задача эксперимента:
Целью эксперимента не было показать, что
церковь - это одна большая бактерия. Просто человек
должен знать, что на иконах, если они их целуют, не так
ли? Понятное дело, что вера тех, кто каждый день ходит в
церковь, сильнее мысли о том, что икона грязная.
Напарница Дарьи сама неоднократно целовала иконы в
церквях. После проекта сказала, что в следующий раз
дважды перед этим подумает.
Во времена эпидемий иконы считались
разносчиками инфекций, и церкви закрывали. Но
разносчиком инфекций может быть и вино. Когда вы
приходите на причастие и стоите в очереди из 20 людей к
кагору, вы выпиваете уже не кагор, а слюни этих 20
людей, и допиваешь лжицу, а потом вы целуете руку, и с
рук она тоже хотела брать анализ.
К тому же ей был интересен и круговорот
людей, где икона выступает как его центр. Этот
эксперимент - еще и попытка запечатлеть ситуацию,
настоящий момент. Служительница подошла к стеклу и все
это смыла, все следы исчезли, потом эти микроорганизмы
набираются на нем снова, и так до бесконечности, пока
есть образ церкви и иконы. И Дарья подумала о том, что
передо ней мог кто-то поцеловать икону, оставив свой
материал, жидкости на стекле, а через пять секунд к ней
подошла она, забрав микроскопические частицы себе.
Понятно, что так можно сказать обо всем: никто и ничто
не стерильно.
Всего мы обошли шесть церквей
Замоскворечья и взяли смывы с десяти икон: Преподобного
Сергия, Воскресения Христа, Серафима Саровского, Святой
Елисаветы, Божией Матери, Крещения Господня, Спиридона
Тримифунтского, "Неупиваемой Чаши".
Большинство бактерий из них
условно-патогенные организмы: стафилококки,
стрептококки, синегнойные палочки, кишечные палочки. У
нас даже было подозрение на сибирскую язву, но в итоге
это оказалась родственная ей палочка. Мы не нашли ни
сифилиса, ни каких-то "жестких" патогенов.
Конечно, я не врач, чтобы делать выводы
о том, насколько обнаруженные микроорганизмы опасны для
здоровья, но, если у тебя слабый иммунитет, они могут
навредить. А то, что иконы не стерильны, - факт. Было бы
здорово, если бы люди протирали за собой иконы салфеткой
с дезинфектором. Ведь это про отношение к ближнему, а
христианство учит любви к нему."
Итак, что было найдено?
Большинство из них условно-патогенные
организмы: стафилококки, стрептококки, синегнойные
палочки, кишечные палочки.
1 Micrococcus luteus - вид
грамположительных неподвижных бактерий-кокков. Их роль в
возникновении заболеваний минимальна (слева).

2 Neisseria sicca - считается нормальным
обитателем носоглотки, но известно, что эта бактерия
способна вызывать сепсис, пневмонию, воспаление сердца,
мозговых оболочек и другие заболевания у ослабленных
больных.
3 Bacillus cereus - вид
грамположительных, спорообразующих почвенных бактерий,
вызывает токсикоинфекции у человека.
***
4 Bacillus subtilis - сенная палочка,
вид грамположительных спорообразующих аэробных бактерий,
представителей рода бациллы (Bacillus). Может вызывать
острый гастроэнтерит. В группе риска находятся
новорожденные, ослабленные, дети с иммунодефицитными
состояниями, а также больные со злокачественными
новообразованиями.
***
5 Staphylococcus aureus - золотистый
стафилококк, наиболее патогенный вид стафилококков,
возбудитель гнойно-воспалительных поражений у человека,
инфекций кожи и мягких тканей.
***
6 Pseudomonas aeruginosa - вид
грамотрицательных подвижных палочковидных бактерий.
Обитает в воде и почве, условно-патогенна для человека,
возбудитель нозокомиальных инфекций. Лечение таких
инфекций сложное, ввиду высокой устойчивости к
антибиотикам.
7 Escherichia coli - кишечная палочка,
вид грамотрицательных палочковидных бактерий, широко
распространенных в нижней части кишечника теплокровных
животных.
***
И что же тогда лицемерно ответил Вахтанг Кипшидзе,
зампредседателя Синодального отдела по взаимоотношению
церкви с обществом и СМИ?
"Данные эксперты, насколько мне
известно, не обладают ни необходимыми разрешительными
документами, ни правами на проведение медицинских или
экспертных действий. Если же рассматривать данную акцию
как акт творческого самовыражения, то подобный акт
является совершенно неуместным в церкви. И вообще, не
только в церкви, а в любом пространстве, которое
является частным и сакральным пространством для многих
людей. Абсолютное большинство настоятелей московских
храмов стремятся соблюдать все необходимые гигиенические
правила в своих приходах"
Spletnik - 10.10.2027.
|